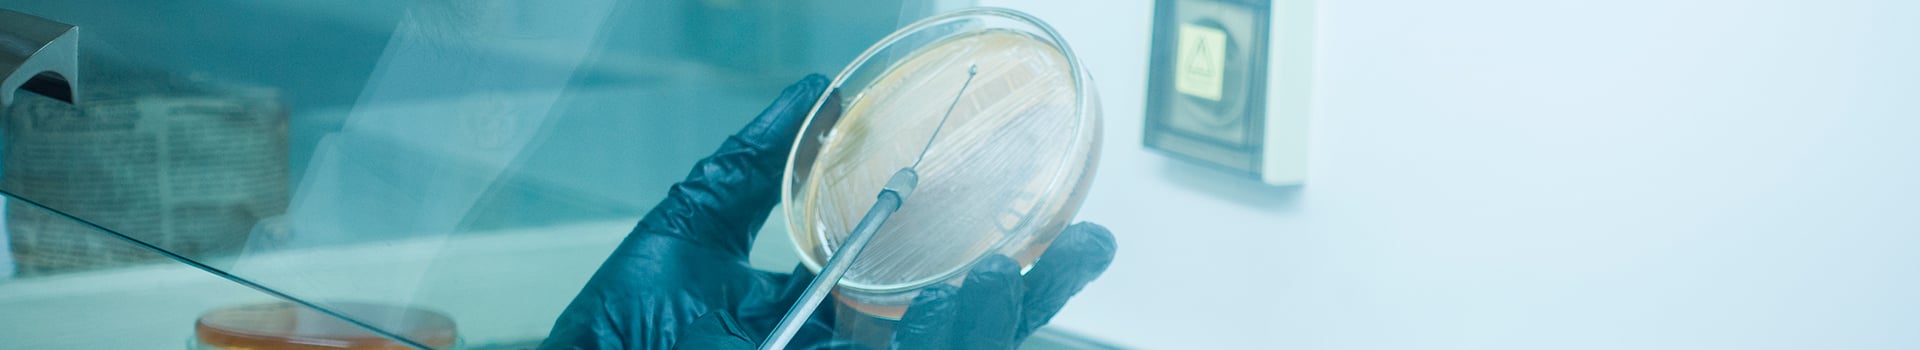
Curso Gratis de Microbiología Clínica: Fundamentos y Aplicaciones en Procesos Infecciosos

Descripción — Curso Gratis de Microbiología Clínica: Fundamentos y Aplicaciones en Procesos Infecciosos
En este Curso Gratis de Microbiología Clínica: Fundamentos y Aplicaciones en Procesos Infecciosos, aprenderás sobre los principios básicos de la microbiología clínica y su importancia en el diagnóstico y tratamiento de enfermedades infecciosas. Se abordarán temas como la identificación de microorganismos patógenos, mecanismos de resistencia a los antimicrobianos y técnicas de diagnóstico microbiológico. Además, se discutirán diferentes estrategias terapéuticas y la importancia de la prevención de infecciones nosocomiales.
Al finalizar el curso, los participantes podrán descargar un certificado de la Sociedad Científica Española de Formación, Docencia e Investigación.
Temario del Curso Gratis de Microbiología Clínica: Fundamentos y Aplicaciones en Procesos Infecciosos
1 Microbiología clínica
- Conceptos generales en microbiología.
- Características de la microbiología.
- Metabolismo bacteriano.
- Taxonomía bacteriana.
- Identificación bacteriana.
- Microorganismos implicados en procesos infecciosos. Bacterias.
- Cocos Gram +.
- Cocos Gram -.
- Género Neisseria.
- Género Brucella.
- Otras bacterias intracelulares.
- Bacilos Gram +.
- Bacilos Gram -.
- Pruebas microbiológicas.
- Coprocultivo, coproparasitario.
- Exudado vaginal.
- Exudado endocervical.
- Exudados uretrales.
- Enfermedades de transmisión sexual.
- Gonorrea.
- Chlamydia.
- Sífilis (Treponema pallidum).
- Herpes (virus herpes simple tipo 1 y 2, VHS).
- Verrugas genitales/PVH (papilomavirus humano - PVH).
- Infección por VIH, SIDA.
- Hepatitis B.
- Hepatitis A.
- Vaginitis (Trichomonas).
- Exudados conjuntivales.
- Raspados corneales.
- Exudados óticos.
- Exudado faríngeo y nasofaríngeo.
- Exudado faríngeo.
- Cavidad orofaríngea.
- Senos paranasales.
- Exudado nasal.
- Técnicas generales en microbiología.
- Medios de cultivo y preparación.
- Condiciones generales para el cultivo de microorganismos.
- Hemocultivos.
- Técnicas de siembra de muestras biológicas.
- Técnicas de tinción en microbiología.
- Tinción de Gram.
- Tinción con rodamina-auramina y con naranja de acridina.
- Tinción de Ziehl-Neelsen (Baar).
- Tinción con blanco de calcoflúor.
- Pruebas de sensibilidad.
- Antibiograma.
- Antibióticos.
- Pruebas de sensibilidad.
- Medios de cultivo y preparación.
- Resumen.
- Autoevaluación.
- Bibliografía.
Acreditación por — Sociedad Científica Europea para la Formación Continua y Capacitación de Profesionales Sanitarios
Este Curso Online Gratuito corresponden a una formación certificada por el organismo "Sociedad Científica Europea para la Formación Continua y Capacitación de Profesionales Sanitarios", con el objetivo de que, como alumno, pueda utilizarlo para actualizar y mejorar sus competencias profesionales y completar su curriculum, además lo podrán emplear para ampliar sus salidas laborales en los distintos puestos de trabajo públicos y privados.
Este sería un ejemplo del certificado emitido únicamente por la Sociedad Científica de las capacitaciones formativas:

Inscríbete en este curso gratis
Completa el formulario y recibirás un email para finalizar tu matrícula
Requisitos
- No haber realizado ningún curso antes con nosotros
- Categoría profesional: Técnicos Superiores en Laboratorio de Diagnóstico